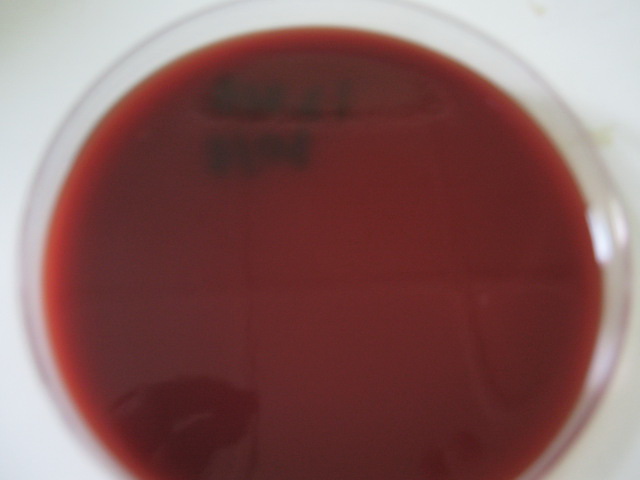

Selektif dan Diferensial Media
Media
Perbenihan yang dapat digunakan untuk memisahkan koloni satu jenis
bakteri dari koloni-koloni lain serta dapat memberi ciri yang khas untuk
bakteri golongan tertentu. Dibawah ini adalah contoh dari selektif dan
differensial media:
Blood Agar Plate (BAP)
Kegunaan:
Untuk isolasi dan pertumbuhan berbagai macam mikroorganisme,terutama
yang phatogen dan menetapkan bentuk hemolisa dari bakteri-bakteri tersebut.
Prinsip
kerja:
Media kultur ini kaya nutrient yang menyediakan kondisi
pertumbuhan yang optimal untuk semua mikroorganisme yang relefan.Ph 6,8
menstabilkan sel darah merah dan menyokong bentuk zona hemolisa yang
jelas. Darah kambing yang di defibrinasi yang segar adalah yang paling
cocok untuk menentukan bentuk hemolisis.
Kandungan:
Nutrien substrat (ekstrak hati dan pepton), NaCl, Agar-agar, Darah kambing
Cara Kerja:
- Suspensi bakteri ditanam dengan cara goresan sejajar pada empat kudaran media.
- Inkubasi 24 jam suhu 370C
- Lihat ciri-ciri koloni.
- Koloni (ingin diperiksa) yang terpisah dapat digunakan untuk pemeriksaan lanjut.
Cara pembuatan:
Larutkan 40 g/L, autoclave (min15 pada suhu 1210C) didinginkan sampai suhunya 45-500C tambah darah yang di defibrinasi campurkan. PH 6,8 ± 0,2 pada suhu 250C
Sebelum penambahan darah, media berwarna bersih coklat kekuning-kuingan, darah berwarna merah dan tidak hemolisis.
Bakteri hemolisa B : S.aureus, S.pyogenes, B.cereus,Cl. Perfringen
Bakteri hemolisa a : K. penumonia
Media selektif bersifat umum untuk bakteri gram positif dan gram negative.
Gambar : BAP yang ditumbuhi bakteri.
Mac Conkey "M"
Kegunaan:
Media selektif dan differensial untuk bakteri gram negative batang
Prinsip
kerja:
Garam empedu dan Kristal violet menghambat pertumbuhan bakteri
gram positif. Laktosa dan PH indicator merah netral digunakan untuk
mendeteksi penurunan laktosa (bakteri yang dapat memfermentasikan
Laktosa atau tidak)
Kandungan:
Pepton dari kasein, pepton dari daging, NaCl, campuran garam empedu, merah netral, Kristal violet, agar-agar.
- Suspensi bakteri ditanam dengan cara goresan sejajar pada empat kudaran media.
- Inkubasi 24 jam suhu 370C
- Lihat ciri-ciri koloni.
- Koloni (ingin diperiksa) yang terpisah dapat digunakan untuk pemeriksaan lanjut.
Cara pembuatan:
Larutkan 50g/L, autoclave 15 menit 1210C, tuangkan pada plate, PH 7.1 ± 0.2 pada suhu 25 0C
Gambar : Mac Conkey agar plate yang ditumbuhi bakteri.
Manitol Salt Agar (MSA)
Kegunaan:
Madia selektif dan differensial media bersifat yang bersifat khusus
(bakteri tertentu),untuk mendeteksi bakteri Staphylococcus petogen ( S. aureus)
Prinsip
kerja:
Hanya mikroorganisme yang tahan terhadap garam yang dapat
tumbuh pada media ini, karena konsentrasi garamnya yang tinggi.Penurunan
dari manitol, warna berubah dari merah menjadi kuning penanda
Staphylococcus yang phatogenic s. aureus( koloni kecil )
Kandungan:
Pepton, ekstrak daging, manitol, sodium klorida, manitol, phenol red,agar2.
Hasil Positif (tersangka) : koloni kecil warna media di sekotar koloni berubah dari merah menjadi kuning.
Cara Kerja:
- Suspensi bakteri ditanam dengan cara goresan sejajar pada empat kudaran media.
- Inkubasi 24 jam suhu 370C
- Lihat ciri-ciri koloni.
- Koloni (ingin diperiksa) yang terpisah dapat digunakan untuk pemeriksaan lanjut.
Cara pembuatan:
Larutkan 108 g/L autoclave (15 menit pada suhu 121 0C),tuang pada plate PH 7.4 ± 0.2 pada suhu 25 0C.
Staphylococcus aureus mampu memfermentasikan media ini(merah menjadi kuning).
Gambar : MSA agar yang ditumbuhi bakteri yang dapat mefermentasikan manitol,
TBX
Kegunaan : Media selektif khusus untuk bakteri E. coli
Gambar : TBX yang di tumbuhi bakteri E. coli
TCBS (Thiosulfate Citrat Bile Sucrose agar)
digunakan untuk isolasi dan pertumbuhan selektif dari Vibrio cholera dan vibrio enterophatogenic yang lain.
Prinsip
kerja:
konsentrasi thiosulfat dan citrate dan dan kuatnya alkalinitas
dari media ini sebagian besar menghambat pertumbuhan enterobactericeae.
Empedu lembu jantan dan coklat terutama menekan enterococci. Beberapa
bakteri colifirm, yang mungkin bisa tumbuh tidak metabolisme sucrose.
Hanya sedikit strain proteus yang sucrose positif ddapat tumbuh berwarna
kuning seperti koloni Vibrio.Pencampuran indicator bromothymol-biru
menubah warna menjadi biru, kemudian asam dibentu meskipun di media yang
alkalinitasnya kuat.
Kandungan:
pepton dari kasein, pepton dari daging, ekstrak yeast, NaCl, sucrose,
sodium chloride, empedu lembu jantan,sodium choklate,iron (III) citrat
Agar-agar.
Pembuatan:
Larutkan 88g/L dan tuangkan ke plate.
Jangan diautoclave PH 8.6±0.2 pada suhu 25 0C.
Gambar : TCBS yang ditumbuhi bakteri V. cholera
SS( Shalmonella Shigella)
Kegunaan:
Untuk isolasi salmonella dan shigella.
Prinsip
kerja:
Briliant green,dan empedu lembu jantan dan konsentrasi tinggi
thiosulfat dan citrate sebagian besar menghambat mikroba yang
mengiringi.sulfida yang diproduksi dideteksi dengan penggunaan
thiosulfation dan besi. Keberadaan bakteri coliform ditetapkan oleh
deteksi penurunan laktosa ke asam dengan Ph indicator merah netral.
Kandungan:
pepton ,laktosa, empedu lembu jantan, Nacitrat, natrium thiosulfat,
ammonium besi (III) ctrat, brilliant green, netral re, agar-agar.
Pembuatan:
larutkan 60g/L secarar sempurna,tuangkan kedalam plate.
Jangan autoclave PH 7.0±0.2 pada suhu 25 0C.
SPS( Sulfite Polimyxin sufadiazine )
Kegunaan:
Untuk isolasi dan perhitungan clostridium perfringen dan clostridium perfringen semua tipe dari bahan makanan.
Prinsip
kerja:
Sulfite polymixin Sulfadiazin Agar berisi nutrient yang
spectrum nya luas.Sulfit direduksi sebagian besar clostridium(termasuk
Cl. Perfringen) menjadi sulfide,yang bereaksi dengan besi citrate dan
menyebabkan koloni berubah menjadi hitam. Mikroorganis me lain yang dapt
mereduksi sulfit di tekan oleh polymixin dan sulfadiazine.
Kandungan:
Pepton dari kasein, ekstrak yeast, besi (III) citrate, sodium sulfat,
polimixin B sulfate, sodium sulfadiazine, agag-agar.
Cara pembuatan:
Larutkan 40g/ liter autoclave ( 15 menit 121 0C) PH 7.0±0.2 pada suhu 25 0C. pertumbuhan dari clostridia yang sensitive sulfit yang juga di pelihatkan
BK (Brusella Kanamisin)
Kegunaan:
Untuk media selektif khusus untuk bakteri Clostridium,dengan penambahan Disk Obat Metronidase.
*Clostridium sensitive dengan metronidase.
Cetrimide
Untuk isolasi dan difrensiasi pseudomonas aerogenosa dari berbagai Janis bakteri lainya.
Prinsip
kerja:
Cetrimide sebagian besar menhambat pertumbuhan bakteri yang
yang mengiringi pertumbuhan Ps. Aerogenosa.Konsentrasi ).3g/L menhambat
bakteri yang mengiringi dengan memuasakan dan meminimalkan gangguan
terhadap pertumbuhan Ps. Aerogenosa.Produksi pigmen tidak dihambat
sewaktu tumbuh pada media ini.Warna pigmen kuning-hijau.
Kandungan:
Pepton dari gelatin, magnesium klorida, potassium sulfat, ccetrimide, agar-agar.
Cara pembuatan:
Laruutkan 44.5 g/L tambah 10 ml gliserol/L,autoclave (15 menit 121 0C)tuangkan ke plate.PH 7 .0±0.2
Gambar : Cetrimide yang ditumbuhi bakteiri Pseudomonas aerogenosa.
KF Streptococccus
Kegunaan:
Media selektif Sterptococcus spesies Enterococci .Untuk deteksi dan penghitungan enterococci.
Prinsip
kerja:
Maltose dan dan lactose di metabolism sebagian besar
enterococci dengan dengan produsi asam dan jadi menignkatkan pertumbuhan
bakteri ini,mikroorganisme yang tidak diinginkan sebagian besar ditekan
sodium acid. Bentuk asam dideteksi oleh bromcresoll ungu dengan
perubahan warna ke warna media menjadi kuning. Enterococci menurunkan
TTC memberi fomazan merah dan jadi terlihat sebagai koloni yang berwarna
merah.
Kandungan:
Proteose pepton, extrack yeast, sodiumclorida, sodium
glicerolphopat, maltose, lactose, sodiumacid, bromocresol purple, agar2,
triphenil tetrazolium acid.
Hasil
positif (tersangka):
enterococcus faecalis, E.hirae dan E. eqiunus
koloni berwarna merah dengan zona kuning disekitar koloni.
Cara pembuatan:
76,4 gram dilarutkan dalam 1L aquadest kemudian sterilkan dengan autoclave 121 0C selama 5 menit.Kemudian ditambah Triphenil tetrazolium Clorid 1%(1ml/100 ml larutan) ketika suhu 5 0C. Tuang di petridish.
Gambar : KF treptococci yang di tumbuhi enterococci.
Baird Parker
Kegunaan:
untuk isolasi dan penghitungan Staphylococcus aureus pada makanan dan bahan pharmasi menurut BAIRD PARKER (1962)
Prinsip
kerja:
Media ini berisi Lithium clorida dan tilurit untuk menghambat
pertumbuhan mikroba yang mengiringi, sementara sementara pyruvat dan
glysin merangsang pertumbuhan staphylococcus.
Koloni staphylococcus memperlihatkan dua karakteristik utama ketika tumbuh pada medium gelap(gelap karena berisi kuning telur)
- Karakteristik zona dan cincin di bentuk sebagai hasil dari lipolysis dan proteulisis.
- Reduksi dari tellurit ke tellurium membentuk warna hitam.
Reaksi
kuning telur dan reduksi tellurit sering ditemukan terjadi bersama
reaksi koagulasi positif dan dapat jadi petunjuk akhir.
kandungan:
pepto dari kasein, ekstrak daging, ekstrak yeast, Natrium pyruvat, glysin, lithium kolorida, aga-agar,
Tambahan : kuning telur emulsi tellurit, sulphamethazin (jika di minta)
Cara Kerja:
Suspensi bakteri ditanam dengan car goresan sjajar pada empat kuadaran media.
Inkubasi 24 jam suhu 37 0C
Ciri Koloni :
Stphylococcus aureus
:Hitam,berkilap/licin, cembung,tepi putih dikelilingi zona terang.
Cincin gelap dengan zona terang terluhat setelah inkubasi 48jam.
S. epidermidis :Hitam, mengkilap, bentuk tidak tertur, zona gelap mengelilingi koloni setalah inkubasi 24jam.
Foto : Baird Parker yang di tumbuhi bakteri
Yersinnia Selective Agar
Media pertumbuhan selektif untuk Y enterocolitica dan Y pseudituberculosis.
Prinsip:
Mikroorganisme
yang mengirin di hambat sebagian besar oleh campuran
antibiotic(yersinia selective supplement’CIN”)Kristal violet dan garam
empedu.Pertumbuhan yersinia walaupun ditingkatkan oleh piruvat dan
nutrient yang tinggi)yersinia menurun kan keberadaaan manithol ke bentuk
asam,oleh karena itu koloni berubah warna menjadi merah karena
indicator phenol red.
Kandungan:
Pepton
dari kasein, pepton dari daging, ekstrak yeas, mannitol, sodiumpirufat,
sodium clorida, magnesium sulfat, campuran garam empedu, netral red,
cristal violet,agar-agar.
Pembuatan:
Larutkan 58.5 g/Lautoclave, dinginkan sampai suhu 45-50 0C.Tambahkan satu botol kecil CNN ke dalam 500ml media dan campurkan dibawah kondisi sterril,tuangkan dalam plate.
PH 7.4±0.2 pada suhu 25 0C.

No comments:
Post a Comment